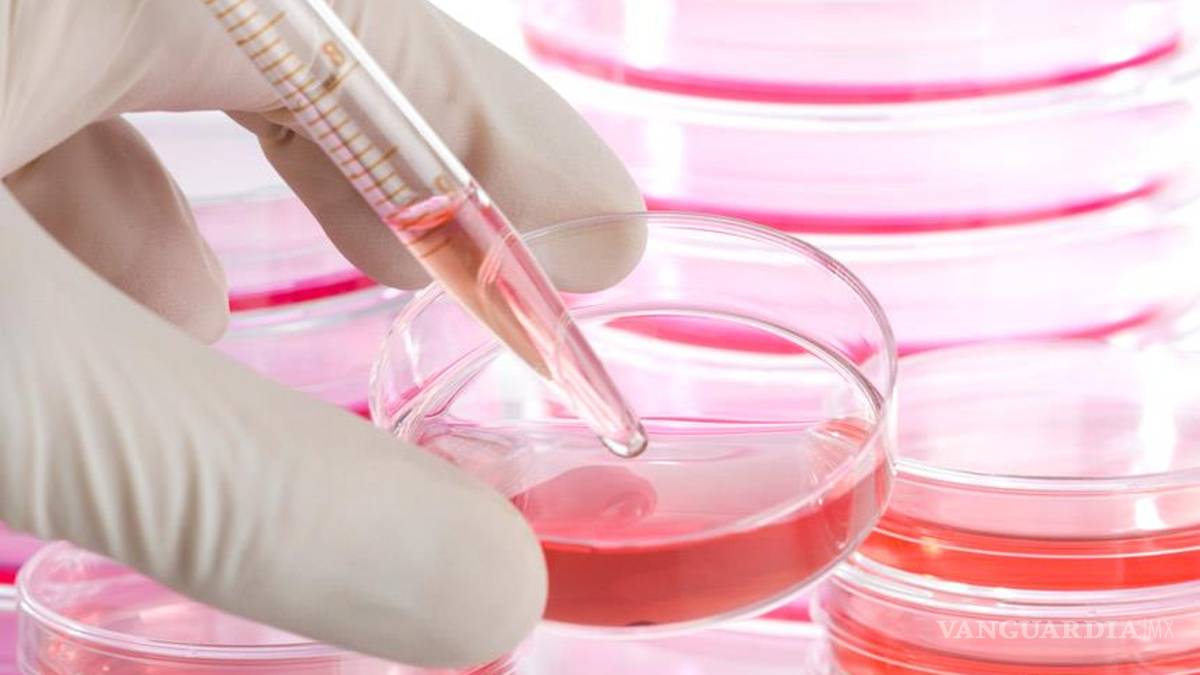

Células madre, ¿la inyección que todo lo cura?
COMPARTIR
El tratamiento de células madre que utilizó Nadal en su rodilla y espalda despierta críticas
Leído recientemente en un tuit de Karim Khan, editor de la revista científica British Journal of Sports Medicine:
Jugador: ¿Las células madre me van a curar el dolor de espalda?
más información
Nadal recurre a las células madre
El último avance en células madre, bajo sospecha
Doctor (mentira): Sí
Doctor (verdad): Ni idea, pero es muy improbable. ¿Quieres ser el conejillo de Indias?.
Seguramente, Rafael Nadal no le verá la gracia al diálogo inventado por el especialista británico, pues el tenista mallorquín es un fiel creyente en la eficacia de las células madre, pero la eficacia y la seguridad del tratamiento despiertan polémica en el mundo científico y entre los traumatólogos desde que su uso halló resonancia mediática por primera vez, cuando, según informó The New York Times, entonces, salvó el hombro y el codo y relanzó la carrera del pitcher de los Yankees Bartolo Colón en mayo de 2011.
A Nadal, un tratamiento con células madre, al que recurrió en noviembre de 2013 después de agotar las posibilidades de los tratamientos anteriores con plasma rico en plaquetas, le solucionó, al menos por un año, los problemas de rodilla. Tan contento quedó Nadal que en noviembre pasado volvió a recurrir a las células madre para curar en este caso sus problemas de espalda, el síndrome facetario (inflamación de una parte de las vértebras lumbares), que le tenía a maltraer. Después de extraer las células madre, las que son capaces de sustituir o regenerar tejidos dañados, en la médula ósea de la cresta iliaca posterior, en la pelvis, del deportista, se le infiltraron en las facetas articulares, entre los lados de los cuerpos vertebrales. Como Nadal, un buen número de jugadores de la NBA o de la liga norteamericana de fútbol se han sometido a la terapia con células madre desde que comenzó su uso experimental en 2009. Actualmente, según el 2014 World Stem Cell Report (Informe mundial de 2014 sobre células madre), unas 700 clínicas de todo el mundo practican una técnica autorizada por la Agencia Mundial Antidopaje (AMA).
Mi experiencia personal y la de la gente que conozco que usa esas técnicas es muy buena, dice Luis González Lago, traumatólogo español que trabaja en el Baniyas, un equipo de fútbol de Abu Dabi. González Lago, que trabajó antes en el Atlético de Madrid de balonmano, es un gran partidario de la medicina regenerativa, en la que se inscriben los tratamientos con células madre, su último escalón después de los más conocidos de plasma rico en plaquetas (que es similar en cierta forma: mediante la centrifugación de la sangre del paciente se obtienen las plaquetas en las que se encuentran los factores de crecimiento que ayudan a regenerar músculos, ligamentos o tendones) y el Orthokine, que utiliza, además de un sistema de centrifugación, un sistema mecánico de rotura de las plaquetas, obteniendo antiinterleukinas-1, de gran utilidad en procesos degenerativos, y como potente antiinflamatorio endógeno. Creo que la medicina regenerativa es útil, no sólo en lesiones en el ámbito de la traumatología deportiva, sino también en procesos degenerativos articulares, en defectos óseos, en retardos de consolidación de fracturas, en defectos de tejidos por parte de la cirugía plástica y reconstructiva, en cirugía maxilofacial, en quemados, añade González Lago, con un entusiasmo que, evidentemente, no comparten los escépticos.
Uno de estos es Juan Manuel Alonso, miembro del comité médico de la Federación Internacional de Atletismo (IAAF). Evidentemente, no puedo estar a favor de los tratamientos con células madre porque es una terapia aún muy experimental, y se practica sin datos científicos que muestren sus beneficios y sus riesgos a largo plazo, que son desconocidos. No lo veo como algo serio, dice Alonso, colega de Karim Khan en el centro de medicina deportiva Aspetar, en Doha (Qatar). Si los deportistas quieren ser cobayas, adelante, pero tienen que saberlo: éxito dudoso, riesgo desconocido a cambio de una buena cantidad de dinero, unos 7.000 euros por infiltración.
Alerta además, Alonso, que se apoya en la polémica desatada en Australia y reflejada en su momento en la revista Nature, de cómo los dueños de las clínicas que ofrecen el tratamiento usan como sostén publicitario los aparentes milagros que logran para sanar lesiones imposibles de deportistas famosos. Ello ha dado nacimiento a una industria muy criticada por la comunidad científica pero que se aprovecha de noticias infundadas de éxito con famosos, se lee en el Nature que refleja los efectos de la operación en la República Dominicana de Colón.
Usamos células adultas, no procedentes de embriones, y procedentes del propio paciente, lo que limita los posibles efectos secundarios. Es verdad que, por el escaso tiempo de utilización y por la dificultad de homogeneizar pacientes y casos para hacer series, no hay trabajos publicados en revistas científicas serias que avalen de forma inequívoca su utilidad, reconoce González Lago. Pero, repito, mi experiencia es buena.








